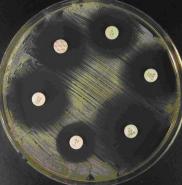

-
συσκευασία 10τμχ.Τιμή με ΦΠΑ: 7.53€
-
συσκευασία 10τμχ.Τιμή με ΦΠΑ: 8.43€
-
συσκευασία 10τμχ.Τιμή με ΦΠΑ: 6.70€
-
συσκευασία 10τμχ.Τιμή με ΦΠΑ: 7.32€
-
Τρυβλία Mannitol Salt Agar (Chapman)
συσκευασία 10τμχ.Τιμή με ΦΠΑ: 7.94€ -
συσκευασία 10τμχ.Τιμή με ΦΠΑ: 6.70€
-
συσκευασία 10τμχ.Τιμή με ΦΠΑ: 6.69€
-
συσκευασία 10τμχ.Τιμή με ΦΠΑ: 17.36€
-
Τρυβλία Sabouraud Dextrose Agar
συσκευασία 10τμχ.Τιμή με ΦΠΑ: 6.94€ -
συσκευασία 10τμχ.Τιμή με ΦΠΑ: 7.69€
-
συσκευασία 10τμχ.Τιμή με ΦΠΑ: 13.27€
-
συσκευασία 10τμχ.Τιμή με ΦΠΑ: Επικοινωνήστε μαζί μας